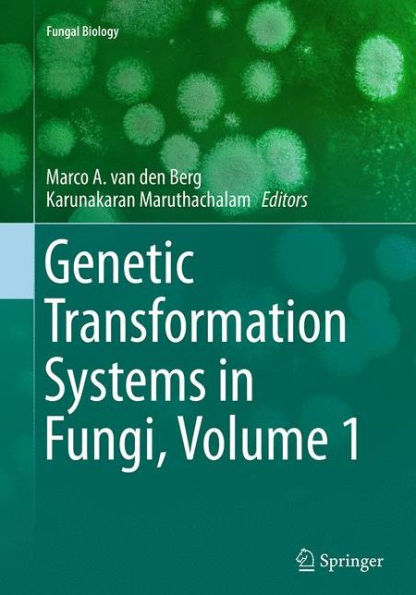
Genetic Transformation Systems Fungi, Volume 1

Home
Achieving sustainable cultivation of temperate zone tree fruits and berries Volume 1: Physiology, genetics
Barnes and Noble
Loading Inventory...
Achieving sustainable cultivation of temperate zone tree fruits and berries Volume 1: Physiology, genetics in Chattanooga, TN
Current price: $180.00

Barnes and Noble
Achieving sustainable cultivation of temperate zone tree fruits and berries Volume 1: Physiology, genetics in Chattanooga, TN
Current price: $180.00
Loading Inventory...
Size: Hardcover
Reviews latest research in tree fruit physiology
Discusses latest developments in genetics and their implications for improved breeding techniques
Comprehensive coverage of key stages in cultivation from nursery plants to water, nutrient and pest management
Discusses latest developments in genetics and their implications for improved breeding techniques
Comprehensive coverage of key stages in cultivation from nursery plants to water, nutrient and pest management
Reviews latest research in tree fruit physiology
Discusses latest developments in genetics and their implications for improved breeding techniques
Comprehensive coverage of key stages in cultivation from nursery plants to water, nutrient and pest management
Discusses latest developments in genetics and their implications for improved breeding techniques
Comprehensive coverage of key stages in cultivation from nursery plants to water, nutrient and pest management